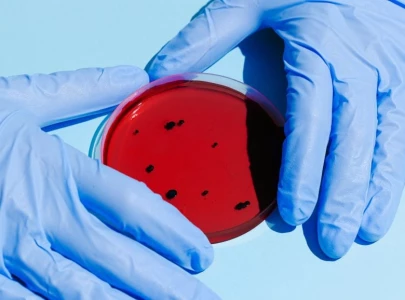
doctors concern over infection diseases vaccination gap in sindh doctors concern over infection diseases vaccination gap in sindh

Stories from Tufail Ahmed
More News
-
Dr Aafia's release 'a matter of days', says Dr Zaidi
Dr Aafia was intercepted in Karachi in March 2003 while travelling with her three children
-
Hospitals deny shelters to patients' caregivers
In the absence of permanent rest areas, low-income attendants are forced to sleep on the sidewalks in winter
-
Hospitals deny shelters to patients' caregivers
In the absence of permanent rest areas, low-income attendants are forced to sleep on the sidewalks in the winter
-
Private healthcare slips through the fingers
In the absence of quality public health services, low-income patients have to empty their pockets for treatment
-
Private healthcare slips through the fingers
During the past three years, doctors have increased their consultation fee by 35 to 50 per cent
-
Physiotherapy still an under acknowledged field
With little job opportunities and meagre pay, physiotherapists seek greener pastures abroad
-
Physiotherapy still an underacknowledged field
With little job opportunities and meagre pay, physiotherapists seek greener pastures abroad
-
Karachi battles surge in seasonal illnesses
Flu cases on the rise as hospitals overflow with patients
-
Doctors concern over infection diseases, vaccination gap in Sindh
Experts also highlighted the horrifying 100% mortality rate of untreated rabies cases and stray dog population
-
Healthcare sickened by complacency
Despite an increase in the health budget, prevention and treatment facilities for low-income patients remained inadequ